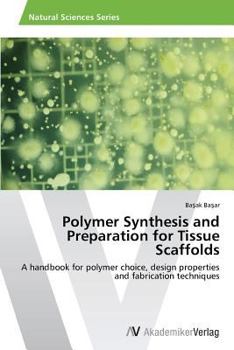
Paperback Polymer Synthesis and Preparation for Tissue Scaffolds Book

Polymer Synthesis and Preparation for Tissue Scaffolds
No Synopsis Available.
Format:Paperback
Language:English
ISBN:3639631005
ISBN13:9783639631005
Release Date:June 2014
Publisher:AV Akademikerverlag
Length:92 Pages
Weight:0.32 lbs.
Dimensions:0.2" x 6.0" x 9.0"
Customer Reviews
0 rating